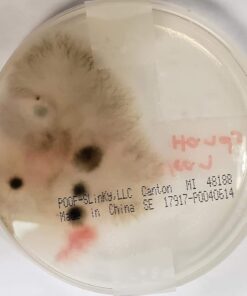
Scientific Explorer Disgusting Science Kit 31 514BRAEU02L
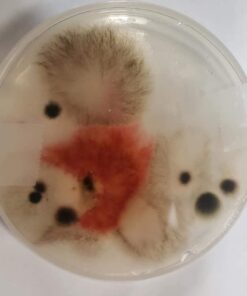
Scientific Explorer Disgusting Science Kit 32 51As7elyT0L
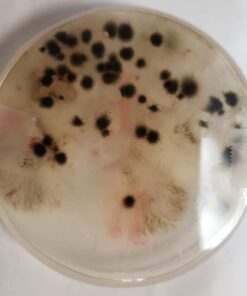
Scientific Explorer Disgusting Science Kit 33 51luPyodoSL
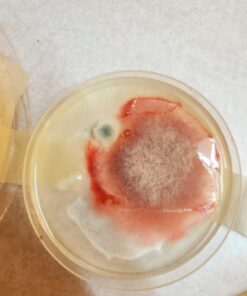
Scientific Explorer Disgusting Science Kit 35 61n LBxothL
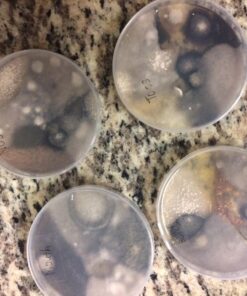
Scientific Explorer Disgusting Science Kit 37 71PB8oQ8 3L

Scientific Explorer Disgusting Science Kit
Description
Scientific Explorer Disgusting Science is the grossest, most revolting kit
available that will educate your child with nasty experiments on what actually
grows on their own body, what’s really in their teeth and the explanations
behind our unmentionable, smelly bodily functions. Disgusting Science
investigates your child’s everyday questions like “What makes you pass gas?”,
“Do creatures really live on me?”, “Why do your feet really stink?” and more.
Your young scientist will be fascinated to learn fun facts about these body
parts, by-products and will be grossed out as they take science to a whole new
level by creating a stinky intestine, slimy snot, fake blood and learn how to
grow friendly molds and bacteria. Recommended for children 8 years of age and
older with adult supervision.
Features:
- Educate your child on what actually grows on their own body
- Learn fun facts about body parts, byproducts and become completely grossed out as you take science to a whole new level
- Create a stinky intestine, slimy snot, fake blood and learn how to grow friendly molds and bacteria
- Includes 4 petri dishes, magnifier, 4 cotton swabs, gelatin, sugar, baking yeast, red and green coloring, rubber balloon, plastic bag and guide
- Recommended for children 8 years of age and older with adult supervision
Product Details:
- Brand: Scientific Explorer
- Theme: Science
- Age Range (Description): Baby,Kid
- Item Dimensions LxWxH: 10 x 2.75 x 12.25 inches
- Item Weight: 0.64 Pounds
- Product Dimensions: 10 x 2.75 x 12.25 inches
- Item Weight: 10.2 ounces
- Item model number: 0SA222
- Manufacturer recommended age: 8 years and up
- Is Discontinued By Manufacturer: No
- Release date: January 1, 2007
- Department: unisex-child
- Manufacturer: Scientific Explorer